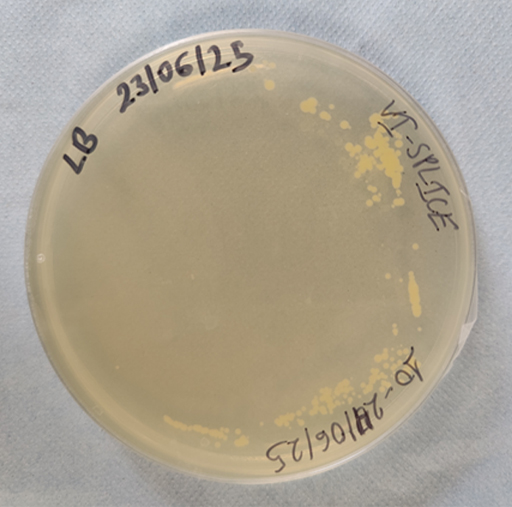
Described image

4.2.2 Monitoring bioburden
Monitoring bioburden during the building of a spacecraft is critical since the bioburden requirements for each mission are dependent on its category as defined in the Planetary Protection Policy (Table 7).
| Table 7 Planetary Protection Policy | ||
|---|---|---|
| Category | Target body (considered to date) | Bioburden requirements |
| I | Asteroids that have experienced significant heating and melting; Io (moon of Jupiter) | No bioburden requirements |
| II (divided into II, IIa and IIb for the Moon) | Venus, Moon, Comets, carbon-rich asteroids, gas giant planets and some of their moons*, some dwarf planets and Kuiper Belt Objects* | contamination avoidance probability <1.0 × 10−4 |
| III | Mars, Europa (moon of Jupiter), Enceladus (moon of Saturn) | ≤5 × 105 spores at launch or <1.0 × 10−4 contamination avoidance probability 50 years after launch |
| IV (divided into a, b and c) | Mars, Europa, Enceladus | ≤3 × 105 spores |
| V ‘Restricted Earth Return’ | Mars, Europa, Enceladus | ≤30 + (2 × 105) spores |
| V ‘Unrestricted Earth Return’ | Venus, Moon | Same as Category I and Category II |
Footnotes
*Additional analysis is required for Ganymede, Titan, Charon, KBOs >1/2 the size of Pluto. Assignment to Category II must be supported by an analysis of the ‘remote’ potential for contamination (a probability of introducing a single viable terrestrial organism e.g., <1 x 104).Monitoring bioburden involves a systematic approach involving sampling, culturing, and quantifying microorganisms.
Sampling is undertaken to monitor bioburden on cleanroom and spacecraft surfaces, as well as within the air and on the personnel working there. Sterile swabs or wipes are used to sample surfaces, hard-to-reach areas, or equipment. The swab or wipe is rubbed over a defined area to collect any microbes present, then the collected microbes are transferred to a growth medium to assess the number of microbes present.
Cleanroom air is samples in two ways. Active sampling involves drawing air through a filter, transferred it to a growth medium, and then assessing the number of microbes per m3 of air (the unit used to represent the number of microbes is explained below). Passive Sampling involves opening a sampling vessel containing growth medium and exposing it to the cleanroom environment for a defined amount of time. Microbes in the air settle onto the growth medium, and the colonies are counted to deduce the microbes per time period.
The cleanroom garments of users are also swabbed to assess the effectiveness of gowning procedures and personnel hygiene. There are also sometimes constraints placed on the number of users permitted into the clean room at any one time.
Culturing is the process by which microbes are grown in a laboratory.
-
If microbes are to be successfully cultured, what will need to be provided?
-
They will need appropriate sources of water, raw materials (nutrients) and energy, and they will need appropriate environmental conditions.
Culturing can be achieved either in a liquid, called a growth medium, or the liquid can be solidified as a firm gel using agar (extracted from seaweed) on the surface of which the microbes can be grown. The medium contains the nutrients and energy sources for the microbes to grow. The usual container for the gel is a small plastic dish with a lid called a Petri dish and a dish of agar is often referred to as an ‘agar plate’. The shape and colour of the microbial colonies that grow on the surface of the gel can then be examined under a microscope (Figure 30). The microorganisms present are quantified using a measure known as ‘colony forming units (CFUs)’. CFUs are a measure of the number of viable microbes that could multiply and form colonies.
This is one example of a biological assay in which the presence of cells or key molecules that comprise cells can be quantified by their response to a chemical environment. Other techniques involve characterising the genetic sequences of the microbes in a cleanroom once sampled.